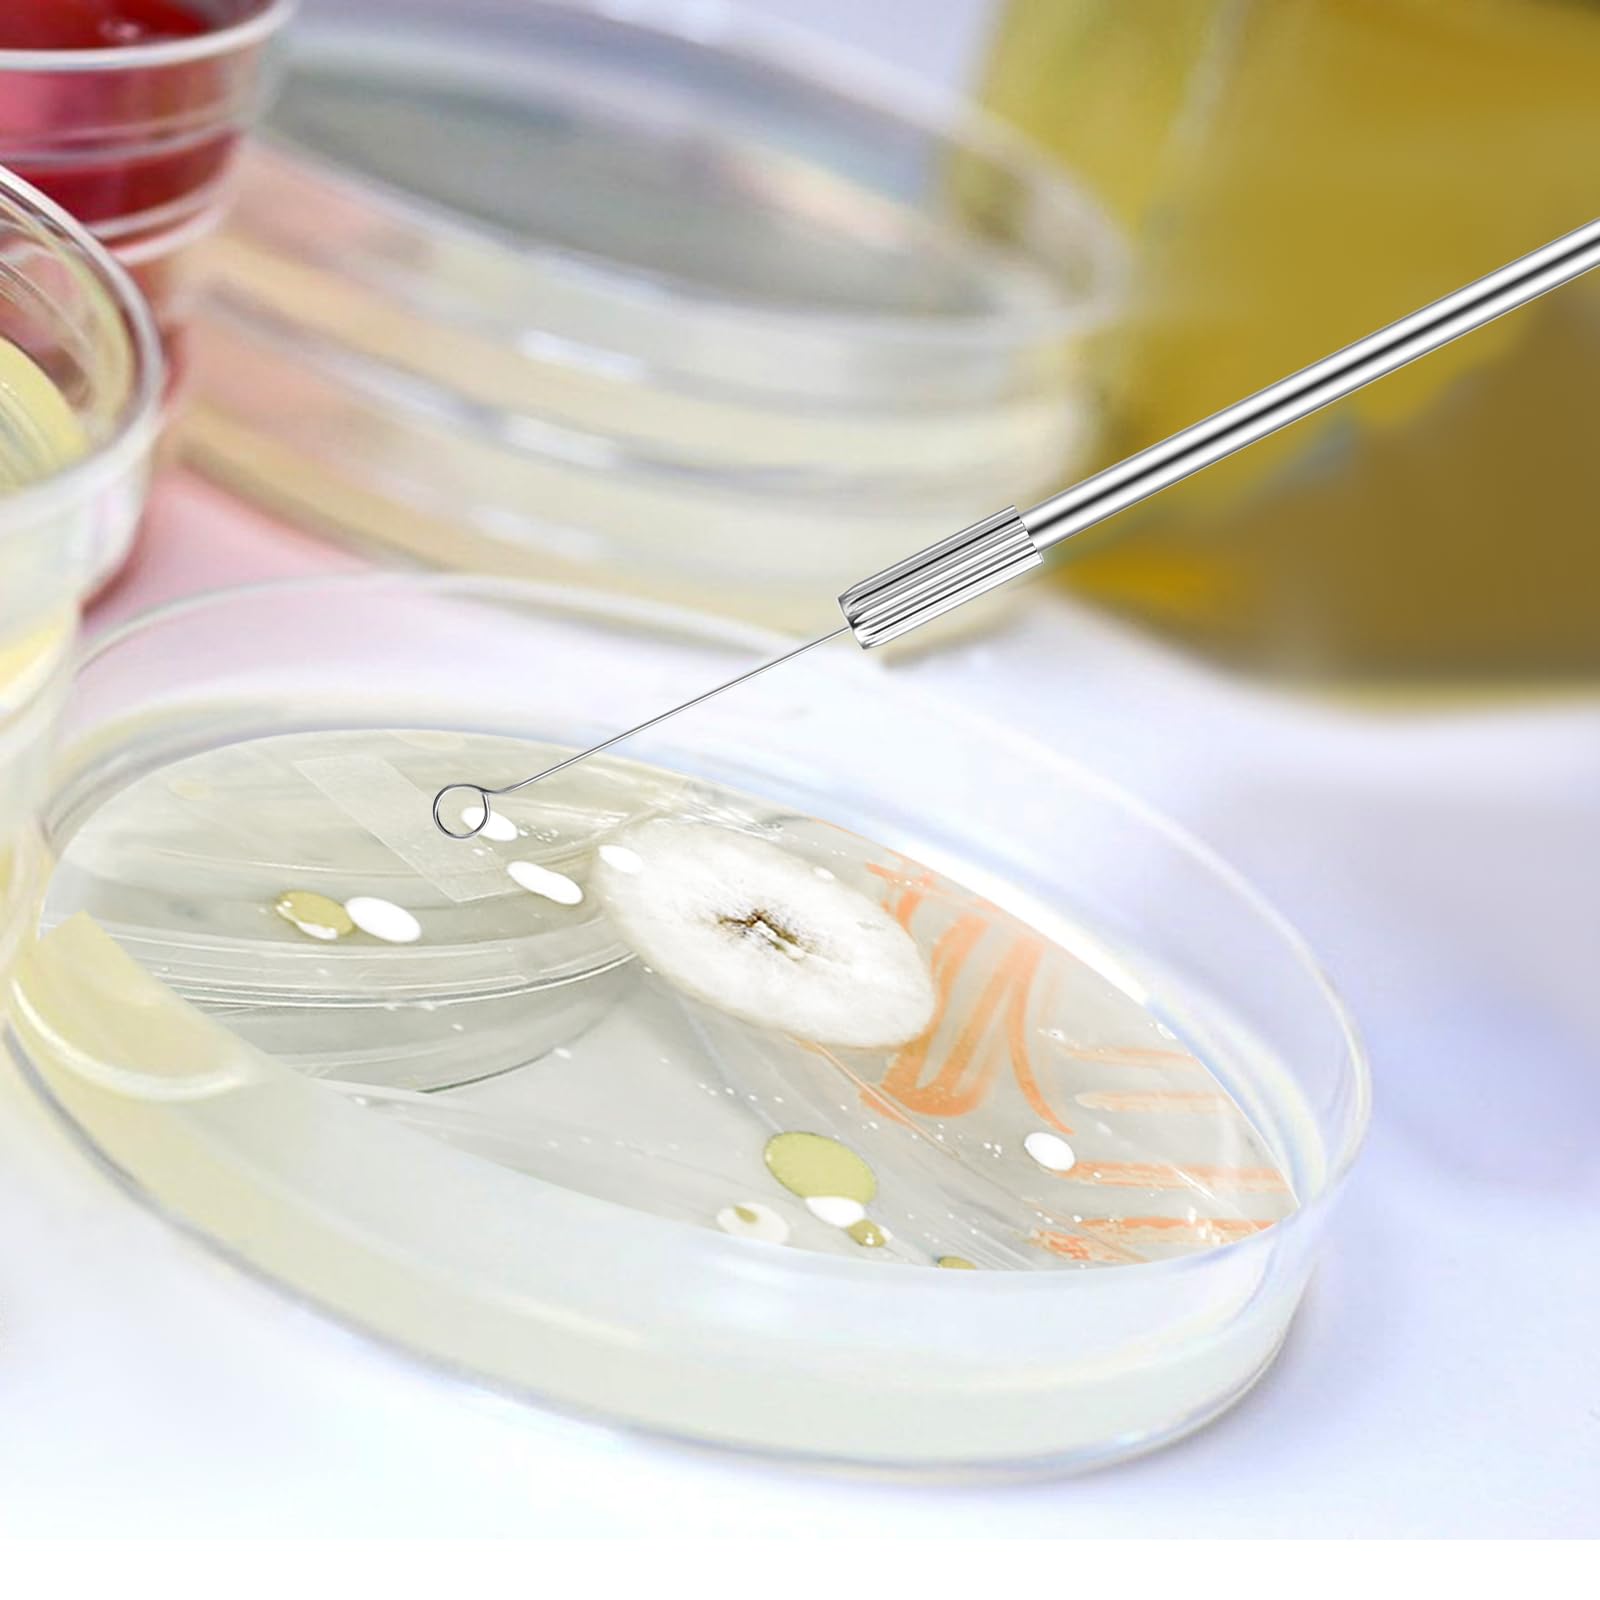
Thumbnail 6

🧬 Elevate your lab game with precision and durability that never quits!
This kit includes two 8.5-inch chrome-plated copper inoculation loops and 70 replaceable chromium alloy needles (35 each of 3mm and 5mm). Designed for durability and ease of use, the lightweight 10g loops offer ergonomic handling and quick needle replacement, making it ideal for precise sample inoculation in mycology and lab research.
Trustpilot
2 days ago
2 weeks ago